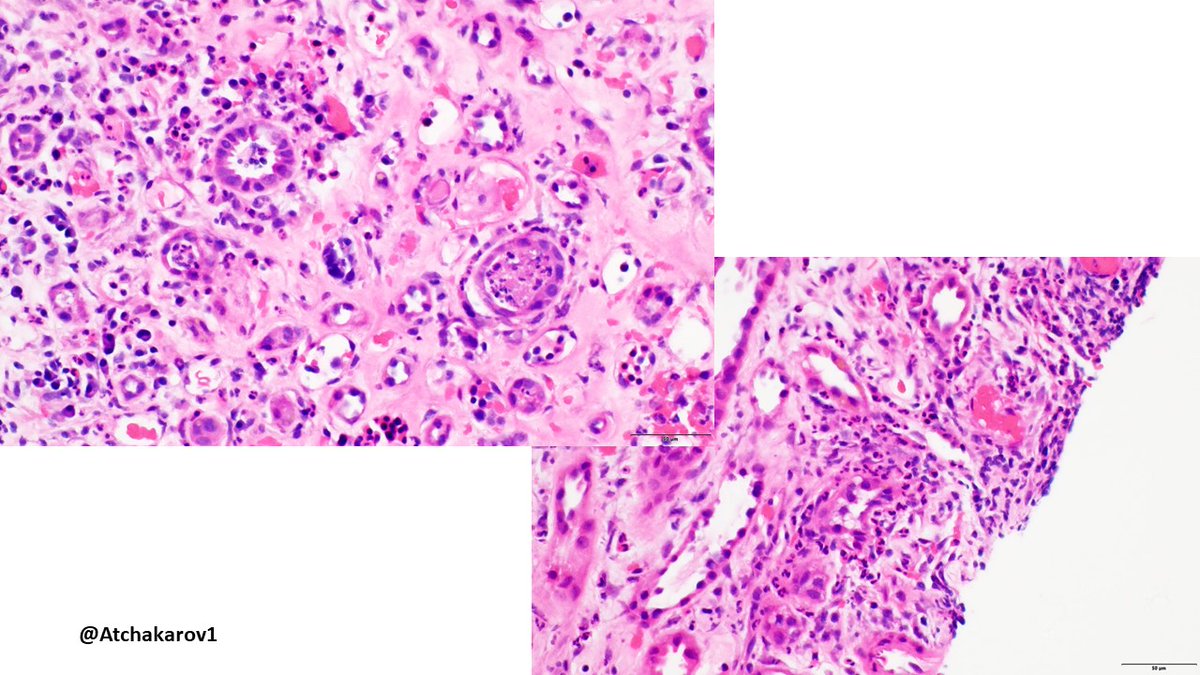
ATchakarov1's tweet image. 👀 look at what&apos;s in the background of this case of pyelonephritis, not used to seeing those cells in a kidney biopsy. #renalpath #nephropath #PathX #PathTwitter
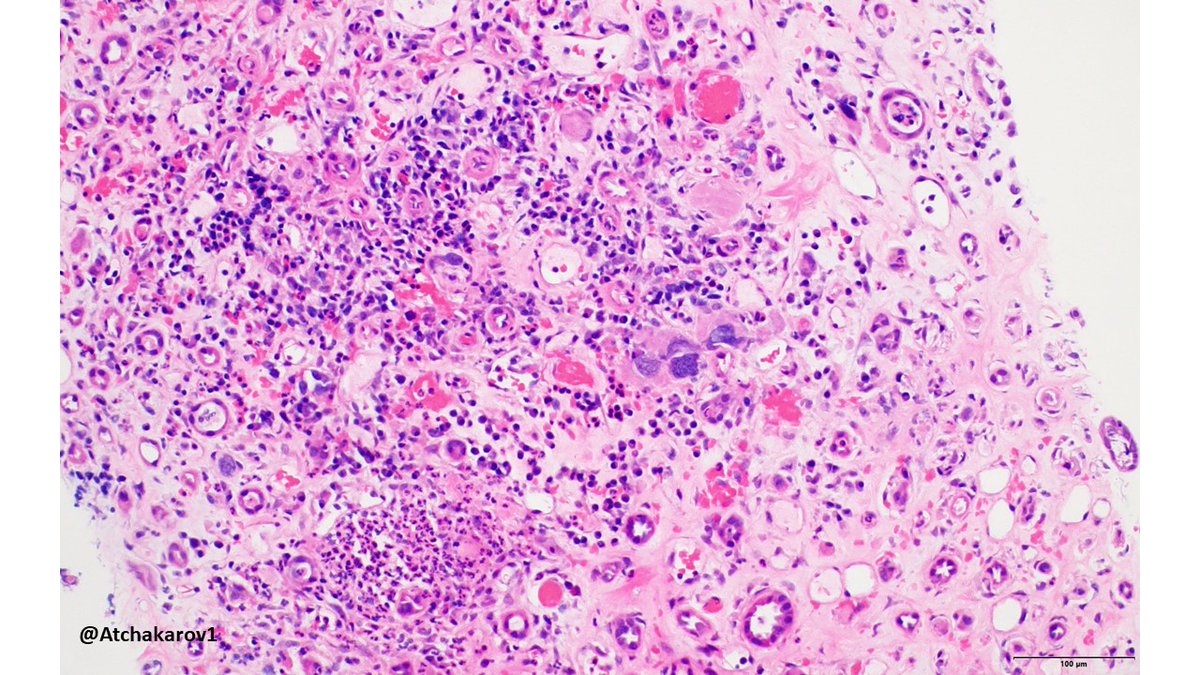
ATchakarov1's tweet image. 👀 look at what&apos;s in the background of this case of pyelonephritis, not used to seeing those cells in a kidney biopsy. #renalpath #nephropath #PathX #PathTwitter
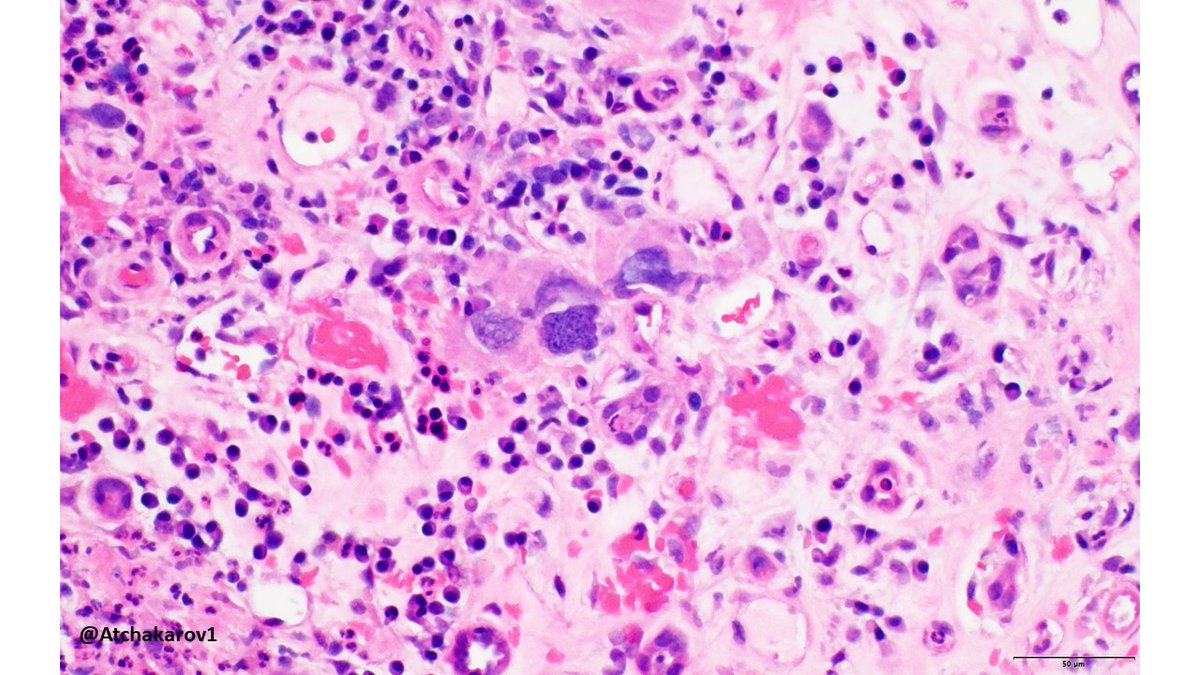
ATchakarov1's tweet image. 👀 look at what&apos;s in the background of this case of pyelonephritis, not used to seeing those cells in a kidney biopsy. #renalpath #nephropath #PathX #PathTwitter

#nephropath نتائج البحث
Biopsia de injerto renal por disfunción con residentes de nefrología @HospitalJuarezM #allografbiopsy #nephropath

BR injerto por disfunción con los residentes de nefrología del @HospitalJuarezM #nephropath #allograftbiopsy #interventionnephrology

Después de mucho tiempo he vuelto a dibujar así que por aquí os dejo unos simpáticos esquemas de biopsias renales, espero que os gusten 🥰 (Intentaré ir subiendo algún dibujillo más) #path #renalpath #nephropath #nephrology #pathology #histology


#Nephropath @glom_busterMD discusses an interesting case of pauci-immune GN with prominent necrotizing arteritis. #MedEd


So much amyloid! This one read the textbook. Negative silver stain. Strong congo red +. Amyloid A IHC positive confirmatory of type AA amyloidosis. #renalpath #nephropath




Great example of the segmental subepithelial deposits in a case of NELL-1 (+) membranous nephropathy. [IgG IF; and NELL-1 IHC pictured]. Notice also NELL IHC shows background podocyte staining; must see deposits stain to call positive. #renalpath #nephropath
![JZRenalPath's tweet image. Great example of the segmental subepithelial deposits in a case of NELL-1 (+) membranous nephropathy. [IgG IF; and NELL-1 IHC pictured]. Notice also NELL IHC shows background podocyte staining; must see deposits stain to call positive. #renalpath #nephropath](https://pbs.twimg.com/media/Fp6PajsaYAAjhNM.jpg)
![JZRenalPath's tweet image. Great example of the segmental subepithelial deposits in a case of NELL-1 (+) membranous nephropathy. [IgG IF; and NELL-1 IHC pictured]. Notice also NELL IHC shows background podocyte staining; must see deposits stain to call positive. #renalpath #nephropath](https://pbs.twimg.com/media/Fp6QKtIacAAh5m8.jpg)
![JZRenalPath's tweet image. Great example of the segmental subepithelial deposits in a case of NELL-1 (+) membranous nephropathy. [IgG IF; and NELL-1 IHC pictured]. Notice also NELL IHC shows background podocyte staining; must see deposits stain to call positive. #renalpath #nephropath](https://pbs.twimg.com/media/Fp6Qaq5aIAAtm8i.jpg)
Everyone's favorite lesion. perinephric artery with endotheliitis. Rest of biopsy showed at most borderline changes. Not diagnostic for rejection by Banff, but always worried about it. Close clinical follow up always recommended. #renalpath #nephropath



Sesión de nefropatología interinstitucional con la Dra. Soto HCIMP- HJM @HospitalJuarezM #nephropath

Nice example of fibrillary GN with prominent sub-epithelial fibril accumulation (sort of mimicking MN). IgG & DNJAB9 stains are pictured. Pt biopsies for CKD with heavy proteinuria. #renalpath #pathtwitter #nephropath




🍏Amyloidosis-Apple green appearance under 🔬 👍Salmon pink on Congo red 👍Apple green under polarising microscope #Nephropath By Dr Arvind at #NZISN @PGINEPHRO

My attempt at poetry @AskRenalPath @arkanalabs @draalok @MVankalakunti @SethiRenalPath @DrGeeONE @smlungpathguy @pembeoltulu @LoboAnandi @drmjkulkarni @VijayPatho @adi_agnihotri @Renalpathsoc @WomenNeph_india #renal #nephropath #renalpath @kriyer68 @rdpatho @pepeheffernan

What is your presumed diagnosis in the absence of immunofluorescence and electron microscopy? #DiagnoseThis #renalpath #nephropath

In the presence of a negative immunofluorescence panel, what is your diagnosis? #DiagnoseThis #renalpath #nephropath

Picture perfect glomerulus done IHC immunohistochemical stain in a renal biopsy of a patient nephrotic range proteinuria 🤩 The blessed beauty of diagnostic nephropathology #RenalPath #NephroPath #Renal #Nephrology

Sclerosed glomeruli In chronic pyelonephritis #MonFunctioningKidney #ChronicPyelonephritis #Nephropath #Pathology #Histopathology #Kidney

👀Nice example of immune complex deposits in lupus nephritis involving the entire kidney, not just the glomeruli (tubular basement membranes, vasculature, interstitium). #RenalPath #Nephropath


Transplant biopsy without viral cytopathic effect, but with granular tubular basement membrane deposits, prompting SV40T staining and revealing BK nephropathy (pvl1). #renalpath #nephropath #transplantpath #pathX #PathTwitter



🍏Amyloidosis-Apple green appearance under 🔬 👍Salmon pink on Congo red 👍Apple green under polarising microscope #Nephropath By Dr Arvind at #NZISN @PGINEPHRO

Usually when I get a renal biopsy for proteinuria in a diabetic patient, it ends up being diabetic nephropathy...but sometimes there's something else going on. 👀🔬 #RenalPath #Nephropath #Nephrology #PathX #PathTwitter



👀 look at what's in the background of this case of pyelonephritis, not used to seeing those cells in a kidney biopsy. #renalpath #nephropath #PathX #PathTwitter

A limited sample showed this lesion and negative staining on paraffin-retrieved IF tissue. What is your diagnosis? #DiagnoseThis #renalpath #nephropath

Biopsia de injerto renal por disfunción con residentes de nefrología @HospitalJuarezM #allografbiopsy #nephropath

BR injerto por disfunción con los residentes de nefrología del @HospitalJuarezM #nephropath #allograftbiopsy #interventionnephrology

Después de mucho tiempo he vuelto a dibujar así que por aquí os dejo unos simpáticos esquemas de biopsias renales, espero que os gusten 🥰 (Intentaré ir subiendo algún dibujillo más) #path #renalpath #nephropath #nephrology #pathology #histology


#Nephropath @glom_busterMD discusses an interesting case of pauci-immune GN with prominent necrotizing arteritis. #MedEd


So much amyloid! This one read the textbook. Negative silver stain. Strong congo red +. Amyloid A IHC positive confirmatory of type AA amyloidosis. #renalpath #nephropath




Sesión de nefropatología interinstitucional con la Dra. Soto HCIMP- HJM @HospitalJuarezM #nephropath

Great example of the segmental subepithelial deposits in a case of NELL-1 (+) membranous nephropathy. [IgG IF; and NELL-1 IHC pictured]. Notice also NELL IHC shows background podocyte staining; must see deposits stain to call positive. #renalpath #nephropath
![JZRenalPath's tweet image. Great example of the segmental subepithelial deposits in a case of NELL-1 (+) membranous nephropathy. [IgG IF; and NELL-1 IHC pictured]. Notice also NELL IHC shows background podocyte staining; must see deposits stain to call positive. #renalpath #nephropath](https://pbs.twimg.com/media/Fp6PajsaYAAjhNM.jpg)
![JZRenalPath's tweet image. Great example of the segmental subepithelial deposits in a case of NELL-1 (+) membranous nephropathy. [IgG IF; and NELL-1 IHC pictured]. Notice also NELL IHC shows background podocyte staining; must see deposits stain to call positive. #renalpath #nephropath](https://pbs.twimg.com/media/Fp6QKtIacAAh5m8.jpg)
![JZRenalPath's tweet image. Great example of the segmental subepithelial deposits in a case of NELL-1 (+) membranous nephropathy. [IgG IF; and NELL-1 IHC pictured]. Notice also NELL IHC shows background podocyte staining; must see deposits stain to call positive. #renalpath #nephropath](https://pbs.twimg.com/media/Fp6Qaq5aIAAtm8i.jpg)
Sesión de nefropatología con residentes de nefrología de @nefrologia_HJM del @HospitalJuarezM y de @NefroHC de @HCentralSLP . Caso muy interesante de GNRP por Lupus Like por HIVICK. #Nephropath #KidneyDisease #kidneybiopsy



My attempt at poetry @AskRenalPath @arkanalabs @draalok @MVankalakunti @SethiRenalPath @DrGeeONE @smlungpathguy @pembeoltulu @LoboAnandi @drmjkulkarni @VijayPatho @adi_agnihotri @Renalpathsoc @WomenNeph_india #renal #nephropath #renalpath @kriyer68 @rdpatho @pepeheffernan

Everyone's favorite lesion. perinephric artery with endotheliitis. Rest of biopsy showed at most borderline changes. Not diagnostic for rejection by Banff, but always worried about it. Close clinical follow up always recommended. #renalpath #nephropath



Nice example of fibrillary GN with prominent sub-epithelial fibril accumulation (sort of mimicking MN). IgG & DNJAB9 stains are pictured. Pt biopsies for CKD with heavy proteinuria. #renalpath #pathtwitter #nephropath




Educational #Nephropath conference. @glom_busterMD discusses an interesting case of IgG4-related tubulointerstitial nephritis. #MedEd #Nephrology

Excellent #Nephropath case discussion of an overlap syndrome (anti-GBM and ANCA) by @glom_busterMD and first year #Nephrology fellow Dr. Batool.



🍏Amyloidosis-Apple green appearance under 🔬 👍Salmon pink on Congo red 👍Apple green under polarising microscope #Nephropath By Dr Arvind at #NZISN @PGINEPHRO

Something went wrong.
Something went wrong.
United States Trends
- 1. Brunson 6,801 posts
- 2. Knicks 12.4K posts
- 3. Celtics 13.2K posts
- 4. Jaylen Brown 6,080 posts
- 5. Duke 27.9K posts
- 6. Jordan Walsh N/A
- 7. #WWENXT 10.7K posts
- 8. Notre Dame 34.7K posts
- 9. Miami 94.3K posts
- 10. Bama 22.9K posts
- 11. Van Epps 125K posts
- 12. Mikal Bridges 1,473 posts
- 13. Tennessee 212K posts
- 14. Isaiah Evans 1,357 posts
- 15. Nashville 32.7K posts
- 16. Behn 77.1K posts
- 17. #kubball N/A
- 18. Boogie Fland N/A
- 19. #RHOSLC 2,644 posts
- 20. Harrison Barnes N/A















































